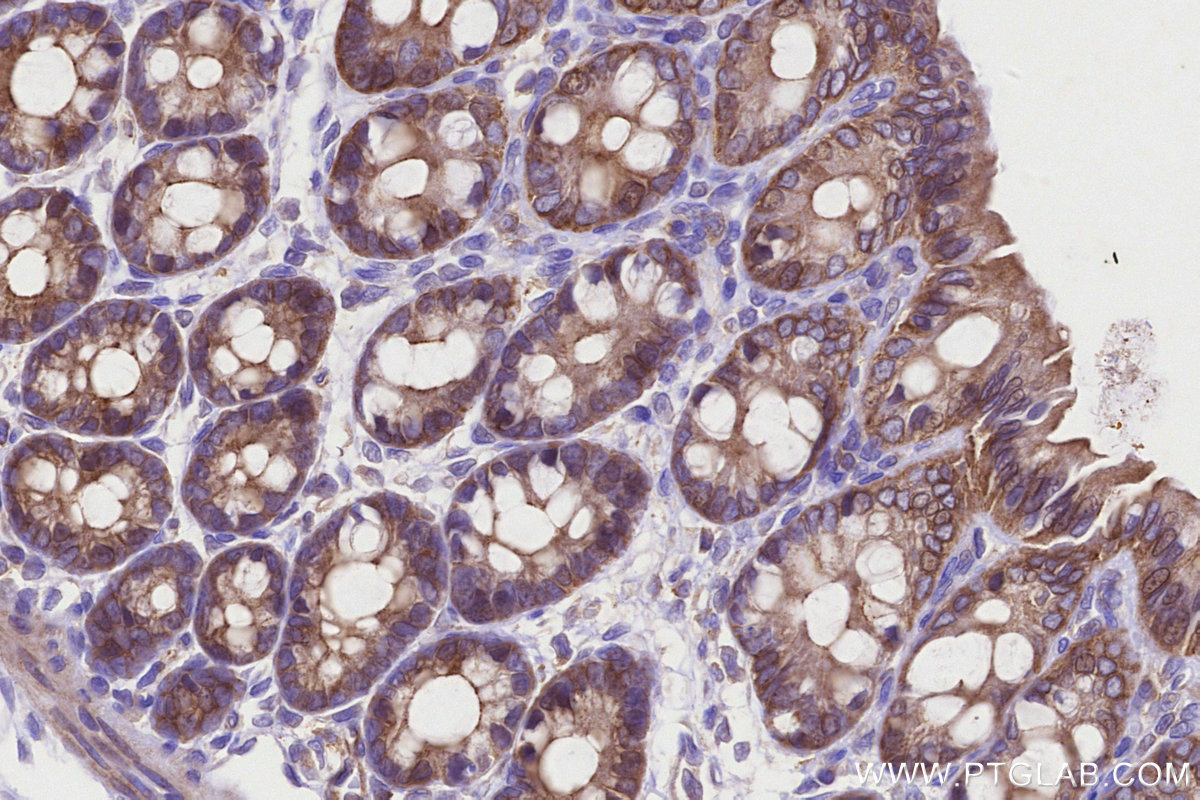
Immunohistochemical analysis of paraffin-embedded rat colon tissue slide using KHC3220 (VASP IHC Kit). Immunohistochemical analysis of paraffin-embedded rat colon tissue slide using KHC3220 (VASP IHC Kit).

IHCeasy® VASP Ready-To-Use IHC Kit
VASP Ready-to-use reagent kit for IHC.
Reactivity
Human, Mouse, Rat
Sample Type
FFPE tissue
Cat no : KHC3220
Synonyms
Vasodilator-stimulated phosphoprotein
Validation Data Gallery
Product Information
KHC3220 is a ready-to-use IHC kit for staining of VASP. The kit provides all reagents, from antigen retrieval to cover slip mounting, that require little to no diluting or handling prior to use. Simply apply the reagents to your sample slide according to the protocol and you're steps away from obtaining high-quality IHC data.
| Product name | IHCeasy® VASP Ready-To-Use IHC Kit |
| Sample type | FFPE tissue |
| Assay type | Immunohistochemistry |
| Primary antibody type | Rabbit Polyclonal |
| Secondary antibody type | Polymer-HRP-Goat anti-Rabbit |
| Reactivity | Human, Mouse, Rat |
Kit components
| Component | Size | Concentration |
|---|---|---|
| Antigen Retrieval Buffer | 100 mL | 50× |
| Washing Buffer | 100 mL ×2 | 20× |
| Blocking Buffer | 5 mL | RTU |
| Primary Antibody | 5 mL | RTU |
| Secondary Antibody | 5 mL | RTU |
| Chromogen Component A | 0.2 mL | RTU |
| Chromogen Component B | 4 mL | RTU |
| Signal Enhancer | 5 mL | RTU |
| Counter Staining Reagent | 5 mL | RTU |
| Mounting Media | 5 mL | RTU |
| Datasheet | 1 Copy | |
| Manual | 1 Copy |
Background Information
VASP belongs to the Ena/VASP family. Ena/VASP proteins are actin-associated proteins involved in a range of processes dependent on cytoskeleton remodeling and cell polarity such as axon guidance, lamellipodial and filopodial dynamics, platelet activation and cell migration. VASP promotes actin filament elongation. It protects the barbed end of growing actin filaments against capping and increases the rate of actin polymerization in the presence of capping protein. VASP stimulates actin filament elongation by promoting the transfer of profilin-bound actin monomers onto the barbed end of growing actin filaments. VASP plays a role in actin-based mobility of Listeria monocytogenes in host cells. Regulates actin dynamics in platelets and plays an important role in regulating platelet aggregation. Human platelet activation is inhibited by agents such as prostaglandins and NO donors, which elevate cAMP or cGMP levels. VASP is phosphorylated in human platelets in response to both cAMP- and cGMP-elevating agents, and its phosphorylation correlates with platelet inhibition.
Properties
| Storage Instructions | All the reagents are stored at 2-8°C. The kit is stable for 6 months from the date of receipt. |
| Synonyms | Vasodilator-stimulated phosphoprotein |